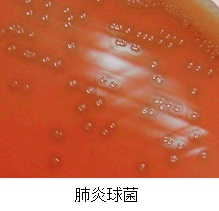

微生物課
ウイルス・細菌検査部門共通の主な業務
感染症発生動向調査
感染症の発生の予防やまん延の防止を目的とし、県内の定点医療機関で採取された検体・分離菌について、病原体の検索や精査をしています。得られた情報は、感染症情報センターがとりまとめている感染症の発生情報と併せて、地域の公衆衛生対策に役立つよう随時ホームページ等で公開しています。
以下をクリックすると、福島県感染症情報センターのページが開きます。
(検査の対象疾患)
インフルエンザ、RSウイルス感染症、咽頭結膜熱、A群溶血性レンサ球菌咽頭炎、感染性胃腸炎、水痘、手足口病、
伝染性紅斑、突発性発しん、百日咳、ヘルパンギーナ、流行性耳下腺炎など
| <ウイルスの分離> |
|
ウイルスは細菌と異なり、自己増殖できません。そのため、生きた細胞(培養細胞)を用いて、ウイルスの培養・分離を行います。 ウイルスが培養細胞に感染し増殖すると、培養細胞に変形や破壊などの特徴的な変化(CPE:細胞変性効果)がみられます。 |
| <細菌の分離> |
|
細菌は栄養を含む(固形状または液状)培地を用いて培養、分離を行います。 血液寒天培地上で肺炎球菌の多くは、周りが緑色になり中央が陥没します。A群溶血性レンサ球菌は、発育すると周辺が透明になります。 |
安全キャビネット シークエンサー

病原体を安全に取り扱うための設備を 塩基配列を解析する機器です。
使用して検査を行っています。 ウイルスや細菌の塩基配列を解析し、
県内の流行をより詳細に調査しています。
調査研究
詳細はこちらをご覧下さい。 (クリックすると調査研究のページが開きます。)
地方衛生研究所衛生微生物協議会 北海道・東北・新潟ブロック支部レファレンスセンター活動
国立感染症研究所及び地方衛生研究所は衛生微生物技術協議会を核としたネットワークを形成し活動しています。全国の地方衛生研究所全てが、様々な感染症に対して高度化する検査技術に対応・維持することは困難なことから、主な感染症・病原体毎に各ブロック内の中心的な研究施設として「レファレンスセンター」が設置されており、「検査技術の維持・継承」、「検査試薬の維持・供給」、「感染症、病原体に関する情報収集・提供」を行っています。
当所は、北海道・東北・新潟ブロック支部における以下のレファレンスセンターを担っています。
- エンテロウイルスレファレンスセンター
- リケッチアレファレンスセンター
- 溶血性レンサ球菌レファレンスセンター
- ボツリヌス菌レファレンスセンター
ウイルス検査部門の主な業務
感染症・食中毒の検査
感染症検査は、麻しん、風しん、デング熱、ジカ熱、MERS、新型インフルエンザ、つつが虫病(疑い事例も含む)などの患者が県内で発生し、検査が必要となった場合に実施しています。食中毒検査は、県内で発生した食中毒(疑い事例も含む)事例についてノロウイルスの検査を実施しています。
感染症流行予測調査(クリックすると詳細ページが開きます。)
予防接種の効果的な運用と、長期的・総合的に感染症の流行を予測することを目的として、厚生労働省が主体となって実施している事業です。病原体に対する社会集団の免疫保有状況を確認する「感受性調査」と、病原体の潜伏状況を調査する「感染源調査」を実施しています。当所では、感受性調査は「インフルエンザ」及び「麻しん」を実施し、感染源調査は「ポリオ」及び「日本脳炎」を実施しています。
HIV・肝炎検査
保健所からの依頼により、患者の早期発見、感染拡大の防止を目的とし、県民のHIV検査、B型肝炎及びC型肝炎ウイルス検査を実施しています。
細菌検査部門の主な業務
感染症・食中毒の検査
県内で検出した腸管出血性大腸菌、赤痢菌、コレラ菌、腸チフス菌、パラチフス菌の菌株は全て当所に搬入され、確認後、国立感染症研究所に送付しています。 感染研では、全国から集められた菌株について遺伝子の解析を行い、各菌株間の比較を行っています。
結核菌の遺伝子解析
結核は感染から発症までに長期間を要する場合や重症化しないと患者本人が結核を疑わない場合も多く、その結果、周囲の人も感染して多くの社会問題となり得る病気です。 当所では保健所の依頼に基づき、結核菌の遺伝子を解析・比較することで、同一の菌株かどうか判定しています。感染経路を科学的根拠に基づいて解明し、感染拡大の防止に努めています。
食品安全対策事業に係る検査
食品の安全性を確保することを目的として、チーズや生乳のリステリア・モノサイトゲネスの検査を行っています。リステリア・モノサイトゲネスはリステリア菌の中で、唯一人畜共通感染症で、ヒトや動物の敗血症、髄膜炎など致命率の高い病原菌です。
医薬品安全対策事業に係る検査
医薬品、医療器具等の有効性・安全性を確保するため、医薬品や医療器具の無菌試験を行っています。具体的には、試験品(チューブ類や縫合糸、採血管など)を液体培地に入れて培養し、菌の発育を認めないことを確認しています。

試験品の一例